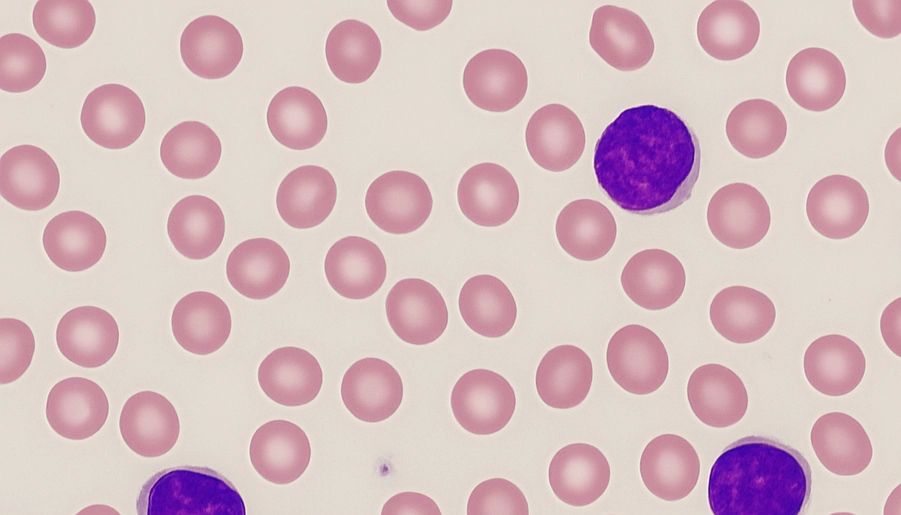

About the Lab
Geffen Kleinstern’s lab focuses on analyzing genome-wide association studies (GWAS), tumor sequencing data, and epidemiological data, to explore the etiology and prognosis of cancer and pre-cancerous conditions, and develop inherited and tumor genetic scores for prediction models. These scores may be used for disease prevention and to improve clinical guidelines in disease management.

Scholar Profile
Geffen Kleinstern’s lab is in the University of Haifa’s School of Public Health in the Faculty of Social Welfare and Health Sciences, where she studies individuals with monoclonal B cell lymphocytosis (MBL), a pre-cancerous condition, who may be at greater risk of progressing to chronic lymphocytic leukemia (CLL). Specifically, she evaluates the prevalence of MBL in the Israeli population as a whole, as well as by ethnicity, and examines whether MBL increases the risk of threat to life due to SARS-CoV-2 infection in these populations.
Dr. Kleinstern is currently leading two major collaborations: the first with Clalit Health Services and Bnai Zion Medical Center, to determine the clinical consequences and genetic risk of low count monoclonal B-cell lymphocytosis (LC MBL a). This common premalignant condition affects between 3 and 17 percent of European adults over age 40. Her team aims to identify genetic factors for LC MBL risk using a unique multi-ethnic population of Jews and Arabs in Israel, and evaluate whether this condition increases the risk of life-threatening infections and cancers. The second is collaboration involves a family study of CLL and other lymphoproliferative disorders, together with the Israeli CLL group, which includes 14 Israeli medical centers, and the Mayo Clinic. The team will conduct an epidemiological study of Jewish and Arab families with at least two relatives diagnosed with CLL, and investigate medical history and genetic risk factors for familial CLL in these populations. First-degree relatives of these patients will be screened for monoclonal b cell lymphocytosis (a precursor state to CLL), and medical history and genetic risk factors for this condition will be investigated.
Dr. Kleinstern explored multiple risk factors for B-cell non-Hodgkin lymphoma (B-NHL) in Israeli and Palestinian populations, specifically, environmental, infectious, and genetic, for her doctoral research in Epidemiology and Biostatistics at the School of Public Health in the Faculty of Medicine at the Hebrew University. The most surprising findings were that the mean age at B-NHL diagnosis was 9 years younger in Palestinians compared to Israelis, and the aggressive subtype, diffuse large B-cell lymphoma (DLBCL), was much more common in Palestinians as compared to Israelis.
Dr. Kleinstern was invited to do her postdoctoral research at the Mayo Clinic in Rochester, Minnesota, where she later received an Assistant Professor of Epidemiology rank. She analyzed genome-wide association studies (GWAS), tumor sequencing data, and epidemiological data, to explore the etiology and prognosis of cancer, and develop inherited and tumor genetic scores for prediction models. The scores she identified at the Mayo Clinic with colleagues led to funding from the National Institutes of Health (NIH), which she has applied to her Zuckerman lab at the University of Haifa. Her continued collaboration with Mayo includes exploring whether the scores can bring us closer to identifying individuals with monoclonal B cell lymphocytosis (MBL), a pre-cancerous condition, who may be at greater risk of progressing to chronic lymphocytic leukemia (CLL). She continues to collaborate with oncologists and hematologists in hospitals across Israel, hoping to eventually implement these genetic scores to change clinical guidelines in disease management, using big data to develop personalized medicine.
Dr. Kleinstern heads the Community Health Program at Haifa’s School of Public Health, and was - recently nominated to serve on the Coordinating Committee of the "InterLymph" Consortium, an international lymphoma epidemiology association of more than 100 investigators from over 25 institutions around the world. As an active member of the consortium since 2016, Dr. Kleinstern led several important studies that resulted in high impact publications.
She is a former member of the Israeli National Synchronized Swimming team and was a candidate for the 2004 Olympics.